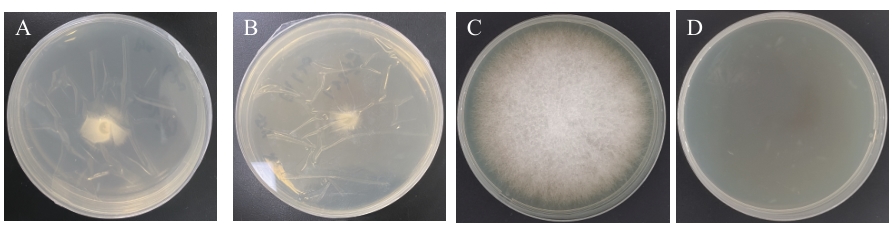
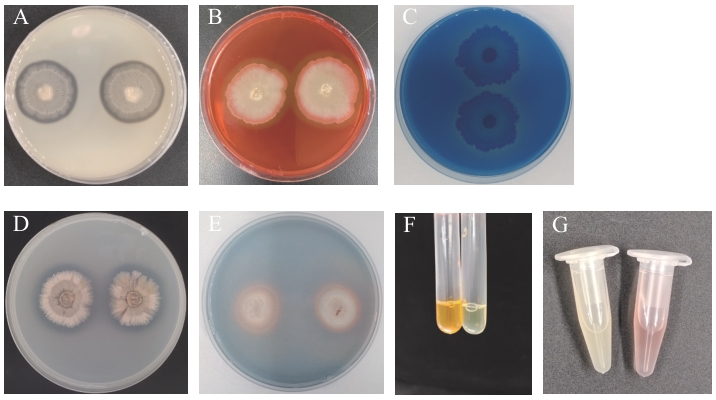

Biotechnology Bulletin ›› 2026, Vol. 42 ›› Issue (4): 272-286.doi: 10.13560/j.cnki.biotech.bull.1985.2025-0891
Previous Articles Next Articles
LIN Bao-mei( ), LI Shan-shan, LI Hai-ming, HONG Jia-min, ZHANG Shuai, WU Miao-hong, WU Wei-jian, WU Shui-jin(
), LI Shan-shan, LI Hai-ming, HONG Jia-min, ZHANG Shuai, WU Miao-hong, WU Wei-jian, WU Shui-jin( )
)
Received:2025-08-18
Online:2026-04-26
Published:2026-04-30
Contact:
WU Shui-jin
E-mail:530228658@qq.com;wsj578659@163.com
LIN Bao-mei, LI Shan-shan, LI Hai-ming, HONG Jia-min, ZHANG Shuai, WU Miao-hong, WU Wei-jian, WU Shui-jin. Screening and Identification of Antagonistic Bacterium against Banana Fusarium wilt and Its Biocontrol Effects[J]. Biotechnology Bulletin, 2026, 42(4): 272-286.
| 评价指标 Evaluation indicator | 病害等级 Pathogen severity grading | 病害描述 Evaluation content description |
|---|---|---|
叶片黄化度 Leaf yellowing degree | 0 | 叶片无症状 |
| 1 | 下部1-2片叶黄化,黄化面积≤25% | |
| 3 | 3-4片叶黄化,25%<黄化面积≤50% | |
| 5 | 外围叶片黄化,黄化面积>50%,叶片萎蔫 | |
| 7 | 大部分叶片黄化、萎蔫,仅叶心正常 | |
| 9 | 植物萎蔫、枯萎死亡 | |
球茎褐变度 Bulb browning degree | 0 | 球茎组织白色,无褐变 |
| 1 | 球茎褐变面积≤25% | |
| 3 | 25%<球茎褐变面积≤50% | |
| 5 | 50%<球茎褐变面积≤75% | |
| 7 | 球茎褐变面积>75% |
Table 1 Disease severity classification of banana Fusarium wilt
| 评价指标 Evaluation indicator | 病害等级 Pathogen severity grading | 病害描述 Evaluation content description |
|---|---|---|
叶片黄化度 Leaf yellowing degree | 0 | 叶片无症状 |
| 1 | 下部1-2片叶黄化,黄化面积≤25% | |
| 3 | 3-4片叶黄化,25%<黄化面积≤50% | |
| 5 | 外围叶片黄化,黄化面积>50%,叶片萎蔫 | |
| 7 | 大部分叶片黄化、萎蔫,仅叶心正常 | |
| 9 | 植物萎蔫、枯萎死亡 | |
球茎褐变度 Bulb browning degree | 0 | 球茎组织白色,无褐变 |
| 1 | 球茎褐变面积≤25% | |
| 3 | 25%<球茎褐变面积≤50% | |
| 5 | 50%<球茎褐变面积≤75% | |
| 7 | 球茎褐变面积>75% |
| 试验项目 Tested item | 结果 Results | 试验项目 Item tested | 结果 Results | ||
|---|---|---|---|---|---|
| 接触酶反应 Catalase reaction | + | V-P试验 Voges Proskauer test | + | ||
| 明胶液化 Gelatine liquefication | + | 甲基红试验 Methyl red test | - | ||
| 吲哚试验 Indole test | - | 苯丙氨酸脱氨酶 Amphetanine dehydrogenase reaction | - | ||
| 淀粉水解 Starch hydrolysis | + | 产氨试验 Ammonia production test | + | ||
| 不同碳源 Different carbon sources | 葡萄糖 Glucose | + | 硝酸盐还原实验 Nitrate reduction reaction | + | |
| 蔗糖 Sucrose | + | 柠檬酸盐试验 Citrate test | + | ||
| D-甘露醇 D-mannitol | + | 不同氮源 Different nitrogen sources | 硝酸钾 KNO3 | + | |
| D-麦芽糖 D-maltdust | + | 硫酸铵 (NH4)2SO4 | + | ||
Table 2 Physiological and biochemical characteristics of strain GX-13
| 试验项目 Tested item | 结果 Results | 试验项目 Item tested | 结果 Results | ||
|---|---|---|---|---|---|
| 接触酶反应 Catalase reaction | + | V-P试验 Voges Proskauer test | + | ||
| 明胶液化 Gelatine liquefication | + | 甲基红试验 Methyl red test | - | ||
| 吲哚试验 Indole test | - | 苯丙氨酸脱氨酶 Amphetanine dehydrogenase reaction | - | ||
| 淀粉水解 Starch hydrolysis | + | 产氨试验 Ammonia production test | + | ||
| 不同碳源 Different carbon sources | 葡萄糖 Glucose | + | 硝酸盐还原实验 Nitrate reduction reaction | + | |
| 蔗糖 Sucrose | + | 柠檬酸盐试验 Citrate test | + | ||
| D-甘露醇 D-mannitol | + | 不同氮源 Different nitrogen sources | 硝酸钾 KNO3 | + | |
| D-麦芽糖 D-maltdust | + | 硫酸铵 (NH4)2SO4 | + | ||

Fig. 3 Phylogenetic analysis of strain GX-13A: The phylogenetic tree based on 16S rRNA sequencing analysis. B: The phylogenetic tree based on whole genome sequencing analysis. Numbers in parentheses are NCBI accession numbers. Numbers at branch nodes present bootstrap value. The scale bar 0.01 and 0.050 indicate sequence variance
| 菌株 Strain | ANI (%) |
|---|---|
| B. subtilis ATCC6051 | 99.35 |
| B. cabrialesii TE3 | 92.41 |
| B. tequilensis ATCC BAA-819 | 91.71 |
| B. halotolerans ZB201702 | 87.43 |
| B. velezensis FZB42 | 77.24 |
| B. amyloliquefaciens ATCC23350 | 77.02 |
| B. paralicheniformis KJ-16 | 72.80 |
| B. australimaris PWG | 71.01 |
| B. pumilus ATCC 7061 | 70.99 |
Table 3 ANI values of strain GX-13 and its related strains
| 菌株 Strain | ANI (%) |
|---|---|
| B. subtilis ATCC6051 | 99.35 |
| B. cabrialesii TE3 | 92.41 |
| B. tequilensis ATCC BAA-819 | 91.71 |
| B. halotolerans ZB201702 | 87.43 |
| B. velezensis FZB42 | 77.24 |
| B. amyloliquefaciens ATCC23350 | 77.02 |
| B. paralicheniformis KJ-16 | 72.80 |
| B. australimaris PWG | 71.01 |
| B. pumilus ATCC 7061 | 70.99 |
病原菌 Pathogenic fungi | 菌落直径 Colony diameter (mm) | 抑制率 Inhibition rate (%) | |
|---|---|---|---|
| 对照 Control | 处理 Treatment | ||
| 西瓜枯萎病菌 F. oxysporum f. sp. niveum | 76.00±0.84 | 44.04±0.24 | 42.04±0.89fF |
| 番茄枯萎病菌 F. oxysporum f. sp. lycopersici | 79.81±0.33 | 46.35±0.90 | 41.93±1.18fF |
| 枇杷炭疽病菌 C. acutatum | 77.03±6.04 | 25.80±0.32 | 66.38±2.32dD |
| 香蕉炭疽病菌 C. musae | 72.53±0.58 | 28.87±0.12 | 60.20±0.24eE |
| 水稻稻瘟病菌 M. oryzae | 76.33±0.09 | 7.87±0.11 | 89.70±0.14aA |
| 葡萄黑霉病菌 A. carbonarius | 77.82±5.53 | 29.83±0.39 | 61.55±2.41eE |
| 茶叶芽枯病菌 P. graminicola | 62.06±0.28 | 9.34±0.09 | 84.95±0.09bB |
| 茶叶轮斑病菌 P. theae | 70.70±0.56 | 13.13±1.10 | 81.43±1.55cC |
Table 4 Antifungal activity of strain GX-13 against eight phytopathogenic fungal species
病原菌 Pathogenic fungi | 菌落直径 Colony diameter (mm) | 抑制率 Inhibition rate (%) | |
|---|---|---|---|
| 对照 Control | 处理 Treatment | ||
| 西瓜枯萎病菌 F. oxysporum f. sp. niveum | 76.00±0.84 | 44.04±0.24 | 42.04±0.89fF |
| 番茄枯萎病菌 F. oxysporum f. sp. lycopersici | 79.81±0.33 | 46.35±0.90 | 41.93±1.18fF |
| 枇杷炭疽病菌 C. acutatum | 77.03±6.04 | 25.80±0.32 | 66.38±2.32dD |
| 香蕉炭疽病菌 C. musae | 72.53±0.58 | 28.87±0.12 | 60.20±0.24eE |
| 水稻稻瘟病菌 M. oryzae | 76.33±0.09 | 7.87±0.11 | 89.70±0.14aA |
| 葡萄黑霉病菌 A. carbonarius | 77.82±5.53 | 29.83±0.39 | 61.55±2.41eE |
| 茶叶芽枯病菌 P. graminicola | 62.06±0.28 | 9.34±0.09 | 84.95±0.09bB |
| 茶叶轮斑病菌 P. theae | 70.70±0.56 | 13.13±1.10 | 81.43±1.55cC |
次级代谢物类型 Types of secondary metabolites | 菌落直径 Colony diameter (mm) | 抑菌率 Inhibition rate (%) | ||
|---|---|---|---|---|
| 对照组 Control | 处理组 Treatment | |||
| 无菌发酵滤液 Sterile fermentation filtrate | 76.02±0.39 | 63.50±0.40 | 16.48±0.79gG | |
| 挥发性代谢产物 Volatile metabolites | 82.09±0.17 | 65.66±0.29 | 20.01±0.30fF | |
| 非挥发性代谢产物 Non-volatile metabolites | 累积3 d Accumulation for 3 d | 82.65±0.3 | 49.89±1.63 | 39.64±2.19eE |
| 累积5 d Accumulation for 5 d | 82.52±0.16 | 32.33±0.2 | 60.82±0.31dD | |
| 累积7 d Accumulation for 7d | 81.75±0.23 | 18.92±0.94 | 76.85±1.19aA | |
| 累积9 d Accumulation for 9 d | 82.06±0.09 | 27.36±0.41 | 66.66±0.53cC | |
| 累积11 d Accumulation for 11 d | 81.14±0.17 | 22.47±0.7 | 72.31±0.89bB | |
Table 5 Antimicrobial activity of secondary metabolites of strain GX-13
次级代谢物类型 Types of secondary metabolites | 菌落直径 Colony diameter (mm) | 抑菌率 Inhibition rate (%) | ||
|---|---|---|---|---|
| 对照组 Control | 处理组 Treatment | |||
| 无菌发酵滤液 Sterile fermentation filtrate | 76.02±0.39 | 63.50±0.40 | 16.48±0.79gG | |
| 挥发性代谢产物 Volatile metabolites | 82.09±0.17 | 65.66±0.29 | 20.01±0.30fF | |
| 非挥发性代谢产物 Non-volatile metabolites | 累积3 d Accumulation for 3 d | 82.65±0.3 | 49.89±1.63 | 39.64±2.19eE |
| 累积5 d Accumulation for 5 d | 82.52±0.16 | 32.33±0.2 | 60.82±0.31dD | |
| 累积7 d Accumulation for 7d | 81.75±0.23 | 18.92±0.94 | 76.85±1.19aA | |
| 累积9 d Accumulation for 9 d | 82.06±0.09 | 27.36±0.41 | 66.66±0.53cC | |
| 累积11 d Accumulation for 11 d | 81.14±0.17 | 22.47±0.7 | 72.31±0.89bB | |
Fig. 5 Effects of non-volatile metabolites of GX-13 on mycelial penetration ability of FOCA: Blank PDA plate+cellophane+FOC. B: Metabolite-containing PDA plate+cellophane+FOC. C: Continued cultivation after removal of cellophane and FOC of A. D: Continued cultivation after removal of cellophane and FOC of B
| 试验项目 Item tested | 结果 Results | 试验项目 Item tested | 结果 Results |
|---|---|---|---|
| 纤维素酶 Cellulase | + | 解有机磷能力 Organophosphate solubility | - |
| β-1,3-葡聚糖酶 β-1,3-glucanase | + | 解无机磷能力 Inorganic phosphorus solubility | + |
| 蛋白酶 Protease | + | 解钾能力 Potassium dissolving effect | - |
| 几丁质酶 Chitinase | - | 固氮能力 Nitrogen fixation capacity | - |
| 产铁载体能力 Iron carrier capacity | + | 产氨能力 NH3 production | + |
Table 6 Disease prevention and growth-promoting characteristics of strain GX-13
| 试验项目 Item tested | 结果 Results | 试验项目 Item tested | 结果 Results |
|---|---|---|---|
| 纤维素酶 Cellulase | + | 解有机磷能力 Organophosphate solubility | - |
| β-1,3-葡聚糖酶 β-1,3-glucanase | + | 解无机磷能力 Inorganic phosphorus solubility | + |
| 蛋白酶 Protease | + | 解钾能力 Potassium dissolving effect | - |
| 几丁质酶 Chitinase | - | 固氮能力 Nitrogen fixation capacity | - |
| 产铁载体能力 Iron carrier capacity | + | 产氨能力 NH3 production | + |
Fig. 7 Enzyme production and growth-promoting potential detection of GX-13 strainA: Protease; B: cellulase; C: β-1,3-glucanase; D: inorganic phosphorus solubility; E: iron carrier capacity; F: NH3 production; G: IAA production capacity

Fig. 8 Distribution of disease severity grades in banana seedlings under different treatmentsCK: Blank control; P: pathogen group; A+P: antagonistic strain+pathogen group; C+P: carbendazim+pathogen group
| 指标Index | 空白对照组Blank control | 拮抗菌组Antagonistic strain group | 病原菌组Pathogen group | 拮抗菌+病原菌组 Antagonistic strain + Pathogen group |
|---|---|---|---|---|
| 株高 Plant height(cm) | 17.45±1.46aA | 19.20±2.74aA | 12.20±1.57bB | 12.95±2.03bB |
| 茎粗 Stem size(mm) | 17.06±0.98aA | 15.97±1.47abA | 10.91±1.67cB | 14.76±1.90bA |
| 粗根数量 Number of coarse roots | 8.17±1.72bB | 11.33±2.07aA | 3.83±1.47cC | 7.33±1.51bB |
| 叶片数量 Leaf number | 8.33±0.58aA | 9.33±1.15aA | 5.83±0.41cB | 8.00±1.00bA |
| 叶长 Leaf length(cm) | 18.83±1.63aAB | 19.25±2.46aA | 15.75±1.51bB | 18.33±1.69aAB |
| 叶宽 Leaf width(cm) | 8.60±0.78abAB | 9.47±1.05aA | 7.55±0.97bB | 8.65±0.79abAB |
| 叶绿素相对含量 Relative chlorophyll content | 53.22±2.86aA | 51.60±4.49aA | 28.63±14.03bB | 47.08±7.87aA |
Table 7 Growth-promoting effects of strain GX-13 on banana seedlings
| 指标Index | 空白对照组Blank control | 拮抗菌组Antagonistic strain group | 病原菌组Pathogen group | 拮抗菌+病原菌组 Antagonistic strain + Pathogen group |
|---|---|---|---|---|
| 株高 Plant height(cm) | 17.45±1.46aA | 19.20±2.74aA | 12.20±1.57bB | 12.95±2.03bB |
| 茎粗 Stem size(mm) | 17.06±0.98aA | 15.97±1.47abA | 10.91±1.67cB | 14.76±1.90bA |
| 粗根数量 Number of coarse roots | 8.17±1.72bB | 11.33±2.07aA | 3.83±1.47cC | 7.33±1.51bB |
| 叶片数量 Leaf number | 8.33±0.58aA | 9.33±1.15aA | 5.83±0.41cB | 8.00±1.00bA |
| 叶长 Leaf length(cm) | 18.83±1.63aAB | 19.25±2.46aA | 15.75±1.51bB | 18.33±1.69aAB |
| 叶宽 Leaf width(cm) | 8.60±0.78abAB | 9.47±1.05aA | 7.55±0.97bB | 8.65±0.79abAB |
| 叶绿素相对含量 Relative chlorophyll content | 53.22±2.86aA | 51.60±4.49aA | 28.63±14.03bB | 47.08±7.87aA |

Fig. 9 Genomic circle mapC1, 3-5: Plasmid genome, C2: Chromosome genome. The outermost circle indicates the size of the genome, with each scale being 5 kb; the second and third circles indicate genes on the positive and negative strands of the genome, with different colors representing different COG functional classifications. The fourth circle is a repeated sequence. The fifth circle indicates tRNA and rRNA, with blue indicating tRNA and purple indicating rRNA. The sixth circle indicates GC content. The yellow part indicates that the GC content in this region is higher than the average GC content of the genome. The higher the peak value, the greater the difference from the average GC content. The blue part indicates that the GC content in this region is lower than the average GC content of the genome. The innermost circle is GC-skew, where dark gray indicates the area where G content is greater than C, and red indicates the area where C content is greater than G
基因簇 ID Cluster ID | 类型Type | 起始Start | 终止End | 相似产物Similar production | 相似度 Similar percentage (%) |
|---|---|---|---|---|---|
| 1 | 核糖体肽类 Ranthipeptide, sactipeptide | 203 800 | 225 871 | 产孢杀伤因子 Sporulation killing factor | 100 |
| 2 | 非核糖体多肽类 NRPS | 357 933 | 421 373 | 表面活性素 Surfactin | 82 |
| 3 | 萜类 Terpene | 1 132 993 | 1 153 506 | - | - |
| 4 | 反式AT型聚酮合酶、类聚酮合酶、Ⅲ型聚酮合酶和非核糖体合成肽transAT-PKS, PKS-like, T3PKS, NRPS | 1 746 963 | 1 852 223 | 杆菌烯 Bacillaene | 100 |
| 5 | 非核糖体多肽类、β-内酯类 NRPS, Betalactone | 1 923 840 | 2 000 876 | 丰原素 Fengycin | 100 |
| 6 | 萜类 Terpene | 2 079 114 | 2 101 012 | - | - |
| 7 | Ⅲ型聚酮合酶 T3PKS | 2 149 489 | 2 190 586 | - | - |
| 8 | 非核糖体多肽类 NRPS | 3 089 896 | 3 137 032 | 杆菌素 Bacillibactin | 100 |
| 9 | 环二肽合成酶 CDPS | 3 423 235 | 3 443 981 | - | - |
| 10 | 核糖体肽类 Sactipeptide | 3 655 591 | 3 677 202 | 枯草菌素 A Subtilosin A | 100 |
| 11 | 其他 Other | 3 680 174 | 3 721 592 | 杆溶菌素 Bacilysin | 100 |
| 12 | 表修饰肽 Epipeptide | 3 940 581 | 3 962 279 | 泰兰他汀A Thailanstatin A | 10 |
Table 8 Predicted secondary metabolite biosynthetic gene clusters in strain GX-13
基因簇 ID Cluster ID | 类型Type | 起始Start | 终止End | 相似产物Similar production | 相似度 Similar percentage (%) |
|---|---|---|---|---|---|
| 1 | 核糖体肽类 Ranthipeptide, sactipeptide | 203 800 | 225 871 | 产孢杀伤因子 Sporulation killing factor | 100 |
| 2 | 非核糖体多肽类 NRPS | 357 933 | 421 373 | 表面活性素 Surfactin | 82 |
| 3 | 萜类 Terpene | 1 132 993 | 1 153 506 | - | - |
| 4 | 反式AT型聚酮合酶、类聚酮合酶、Ⅲ型聚酮合酶和非核糖体合成肽transAT-PKS, PKS-like, T3PKS, NRPS | 1 746 963 | 1 852 223 | 杆菌烯 Bacillaene | 100 |
| 5 | 非核糖体多肽类、β-内酯类 NRPS, Betalactone | 1 923 840 | 2 000 876 | 丰原素 Fengycin | 100 |
| 6 | 萜类 Terpene | 2 079 114 | 2 101 012 | - | - |
| 7 | Ⅲ型聚酮合酶 T3PKS | 2 149 489 | 2 190 586 | - | - |
| 8 | 非核糖体多肽类 NRPS | 3 089 896 | 3 137 032 | 杆菌素 Bacillibactin | 100 |
| 9 | 环二肽合成酶 CDPS | 3 423 235 | 3 443 981 | - | - |
| 10 | 核糖体肽类 Sactipeptide | 3 655 591 | 3 677 202 | 枯草菌素 A Subtilosin A | 100 |
| 11 | 其他 Other | 3 680 174 | 3 721 592 | 杆溶菌素 Bacilysin | 100 |
| 12 | 表修饰肽 Epipeptide | 3 940 581 | 3 962 279 | 泰兰他汀A Thailanstatin A | 10 |
| [1] | de Jesus Rocha A, da Silva Soares JM, dos Santos Nascimento F, et al. Improvements in the resistance of the banana species to Fusarium wilt: a systematic review of methods and perspectives [J]. J Fungi, 2021, 7(4): 249. |
| [2] | Ruan YN, Nong CH, Jintrawet A, et al. A smooth vetch (Vicia villosa Var.) strain endogenous to the broad-spectrum antagonist Bacillus siamensis JSZ06 alleviates banana wilt disease [J]. Front Plant Sci, 2024, 15: 1410197. |
| [3] | Li CL, Xiang DD, Yang S, et al. Fusarium wilt of banana latency and onset detection based on visible/near infrared spectral technology [J]. Agronomy, 2024, 14(12): 2994. |
| [4] | 赵阳, 刘爽, 王志彪, 等. 香蕉枯萎病菌候选效应蛋白FoSSP80能抑制植物免疫反应 [J]. 热带生物学报, 2025, 16(1): 87-97. |
| Zhao Y, Liu S, Wang ZB, et al. Functional characterization of candidate effector FoSSP80 in Fusarium oxysporum f. sp. cubense [J]. J Trop Biol, 2025, 16(1): 87-97. | |
| [5] | 张妙宜, 周登博, 起登凤, 等. 香蕉枯萎病综合防控研究进展 [J]. 中国科学: 生命科学, 2024, 54(10): 1843-1852. |
| Zhang MY, Zhou DB, Qi DF, et al. Research progress on the integrated control of Fusarium wilt disease in banana [J]. Sci Sin Vitae, 2024, 54(10): 1843-1852. | |
| [6] | 李华平, 李云锋, 聂燕芳. 香蕉枯萎病的发生及防控研究现状 [J]. 华南农业大学学报, 2019, 40(5): 128-136. |
| Li HP, Li YF, Nie YF. Research status of occurrence and control of Fusarium wilt of banana [J]. J South China Agric Univ, 2019, 40(5): 128-136. | |
| [7] | Shen NK, Li SY, Li SY, et al. The siderophore-producing bacterium, Bacillus siamensis Gxun-6, has an antifungal activity against Fusarium oxysporum and promotes the growth of banana [J]. Egypt J Biol Pest Control, 2022, 32(1): 34. |
| [8] | Hasan M, Hossain M, Jiang D. New endophytic strains of Trichoderma promote growth and reduce clubroot severity of rapeseed (Brassica napus) [J]. PLoS One, 2023, 18(10): e0287899. |
| [9] | De Simone N, Capozzi V, Amodio ML, et al. Microbial-based biocontrol solutions for fruits and vegetables: recent insight, patents, and innovative trends [J]. Recent Pat Food Nutr Agric, 2021, 12(1): 3-18. |
| [10] | Bubici G, Kaushal M, Prigigallo MI, et al. Corrigendum: biological control agents against Fusarium wilt of banana [J]. Front Microbiol, 2019, 10: 1290. |
| [11] | Yin C, Casa Vargas JM, Schlatter DC, et al. Rhizosphere community selection reveals bacteria associated with reduced root disease [J]. Microbiome, 2021, 9(1): 86. |
| [12] | Guo YQ, Tian L, Zhu XY, et al. Antagonism of Bacillus velezensis ZGE166 against the pathogenic fungi causing corm rot disease in saffron (Crocus sativus L.) [J]. Microb Ecol, 2025, 88(1): 40. |
| [13] | Vibha R, Granada DL, Skariyachan S, et al. In vitro and in silico investigation deciphering novel antifungal activity of endophyte Bacillus velezensis CBMB205 against Fusarium oxysporum [J]. Sci Rep, 2025, 15: 684. |
| [14] | Qi D, Liu Q, Zou L, et al. Taxonomic identification and antagonistic activity of Streptomyces luomodiensis sp. nov. against phytopathogenic fungi [J]. Front Microbiol, 2024, 15: 1402653. |
| [15] | Hernández-Melchor DJ, Guerrero-Chávez AC, Ferrera-Rodríguez MR, et al. Cellulase and chitinase activities and antagonism against Fusarium oxysporum f.sp. cubense race 1 of six Trichoderma strains isolated from Mexican maize cropping [J]. Biotechnol Lett, 2023, 45(3): 387-400. |
| [16] | Solórzano R, Ramírez Maguiña HA, Johnson L, et al. Current progress in microbial biocontrol of banana Fusarium wilt: a systematic review [J]. Agronomy, 2025, 15(3): 619. |
| [17] | Bagy HMMK, Hassan EA, Nafady NA, et al. Efficacy of arbuscular mycorrhizal fungi and endophytic strain Epicoccum nigrum ASU11 as biocontrol agents against blackleg disease of potato caused by bacterial strain Pectobacterium carotovora subsp. atrosepticum PHY7 [J]. Biol Control, 2019, 134: 103-113. |
| [18] | 吴巳雨. 长枝木霉HK16-1抗香蕉枯萎病活性物质的挖掘及抑菌效果分析 [D]. 武汉: 华中农业大学, 2024. |
| Wu SY. Extraction of active substance from Trichoderma longibranchus HK16-1 against banana Fusarium wilt and analysis of antifungal effect [D]. Wuhan: Huazhong Agricultural University, 2024. | |
| [19] | Samaras A, Roumeliotis E, Ntasiou P, et al. Bacillus subtilis MBI600 promotes growth of tomato plants and induces systemic resistance contributing to the control of soilborne pathogens [J]. Plants, 2021, 10(6): 1113. |
| [20] | 张德政, 聂太礼, 杨军, 等. 棉花黄萎病高效拮抗细菌的筛选及其防治效果 [J]. 湖北农业科学, 2024, 63(12): 67-72. |
| Zhang DZ, Nie TL, Yang J, et al. Screening and control effect of highly effective antagonistic bacteria against cotton verticillium wilt [J]. Hubei Agric Sci, 2024, 63(12): 67-72. | |
| [21] | 东秀珠, 蔡妙英. 常见细菌系统鉴定手册 [M]. 北京: 科学出版社, 2001. |
| Dong XZ, Cai MY. Manual for common bacterial system identification [M]. Beijing: Science Press, 2001. | |
| [22] | 赵斌, 何绍江. 微生物学实验 [M]. 北京: 科学出版社, 2002. |
| Zhao B, He SJ. Microbiological experiment [M]. Beijing: Science Press, 2002. | |
| [23] | 毕钰, 张琳, 余红凤, 等. 小麦赤霉病拮抗菌JB7的拮抗活性及鉴定 [J]. 微生物学报, 2024, 64(5): 1580-1592. |
| Bi Y, Zhang L, Yu HF, et al. Antagonistic activity and identification of antagonistic bacteria JB7 against Fusarium head blight [J]. Acta Microbiol Sin, 2024, 64(5): 1580-1592. | |
| [24] | 杨学宇, 谭琳, 沈程文, 等. 茶轮斑病拮抗细菌kc-16的抑菌性能及田间防效 [J]. 微生物学通报, 2024, 51(11): 4560-4573. |
| Yang XY, Tan L, Shen CW, et al. Antimicrobial activity and field control effect of an antagonistic bacterial strain kc-16 against tea gray blight [J]. Microbiol China, 2024, 51(11): 4560-4573. | |
| [25] | 李文博, 张新祺, 赵亚婷, 等. 采前喷施壳寡糖对采后西梅黑斑病的控制 [J]. 食品科学, 2025, 46(7): 283-291. |
| Li WB, Zhang XQ, Zhao YT, et al. Control of postharvest prune black spot disease by preharvest chitosan oligosaccharide spraying [J]. Food Sci, 2025, 46(7): 283-291. | |
| [26] | 黎晓丹,方献平,李水根,等.草莓果生炭疽菌效应子基因CfE4对产孢量及菌丝穿透能力的影响[J/OL].分子植物育种,1-11[2025-12-12]., |
| Fang XP, Li SG, et al. The effect of effector gene CfE4 on conidia production and penetration of Colletotrichum fructicola in strawberry[J/OL]. [2025-5-27]. . | |
| [27] | Hyder S, Gondal AS, Rizvi ZF, et al. Characterization of native plant growth promoting rhizobacteria and their anti-oomycete potential against Phytophthora capsici affecting chilli pepper (Capsicum annum L.) [J]. Sci Rep, 2020, 10: 13859. |
| [28] | 甘林, 代玉立, 刘晓菲, 等. 香蕉枯萎病高效拮抗土著细菌的筛选及其防效 [J]. 西北农林科技大学学报: 自然科学版, 2024, 52(6): 95-105. |
| Gan L, Dai YL, Liu XF, et al. Screening and control efficacies of highly effective antagonistic native bacteria against banana Fusarium wilt [J]. J Northwest A F Univ Nat Sci Ed, 2024, 52(6): 95-105. | |
| [29] | Wang JR, Qin S, Fan RD, et al. Plant growth promotion and biocontrol of leaf blight caused by Nigrospora sphaerica on passion fruit by endophytic bacillus subtilis strain GUCC4 [J]. J Fungi, 2023, 9(2): 132. |
| [30] | Sun WL, Shahrajabian MH, Soleymani A. The roles of plant-growth-promoting rhizobacteria (PGPR)-based biostimulants for agricultural production systems [J]. Plants, 2024, 13(5): 613. |
| [31] | 黄勋, 刘霞, 邓琳梅, 等. 马铃薯疮痂病生防菌1X1Y的鉴定及其生防促生特性研究 [J]. 园艺学报, 2025, 52(1): 229-246. |
| Huang X, Liu X, Deng LM, et al. Identification and study on its biocontrol and growth promoting properties of Bacillus velezensis 1X1Y against potato common scab [J]. Acta Hortic Sin, 2025, 52(1): 229-246. | |
| [32] | Yang P, Yuan P, Liu WS, et al. Plant growth promotion and plant disease suppression induced by Bacillus amyloliquefaciens strain GD4a [J]. Plants, 2024, 13(5): 672. |
| [33] | 邓玉莲, 谭琳, 吉进军, 等. 茶树根腐病拮抗真菌的筛选、鉴定及防病促生特性研究 [J]. 中国生物防治学报, 2024, 40(4): 914-926. |
| Deng YL, Tan L, Ji JJ, et al. Screening and identification of antagonistic fungi against root rot of tea plants and their effect on disease control and plant growth promotion [J]. Chin J Biol Control, 2024, 40(4): 914-926. | |
| [34] | Dutilloy E, Arias AA, Richet N, et al. Bacillus velezensis BE2 controls wheat and barley diseases by direct antagonism and induced systemic resistance [J]. Appl Microbiol Biotechnol, 2024, 108(1): 64. |
| [35] | Dai MM, Liu R, Jiang H, et al. Volatile organic compounds of Bacillus pumilus strain S1-10 exhibit fumigant activity against Meloidogyne incognita [J]. Plant Dis, 2023, 107(10): 3057-3063. |
| [36] | Guevara-Avendaño E, Bravo-Castillo KR, Monribot-Villanueva JL, et al. Diffusible and volatile organic compounds produced by avocado rhizobacteria exhibit antifungal effects against Fusarium kuroshium [J]. Braz J Microbiol, 2020, 51(3): 861-873. |
| [37] | 刘高强, 李新鹏, 刘文钊, 等.一株高效降解血液蛋白的枯草芽孢杆菌NWMCC0137全基因组测序及分析 [J]. 江苏农业学报, 2023, 39(7): 1460-1471. |
| Liu GQ, Li XP, Liu WZ, et al. Whole genome sequencing and analysis of Bacillus subtilis NWMCC0137, an efficient blood protein degrading strain [J]. Jiangsu J Agric Sci, 2023, 39(7): 1460-1471. | |
| [38] | 万青. 一株贝莱斯芽孢杆菌对香蕉枯萎病生防作用的研究 [D]. 海口: 海南大学, 2021. |
| Wan Q. Study on the biocontrol effect of a Bacillus velezensis on banana Fusarium wilt [D]. Haikou: Hainan University, 2021. | |
| [39] | 李恒, 畅文军, 陈汉清, 等. 香蕉枯萎镰刀菌4号生理小种mon1基因敲除转化子的表型分析及致病力测定 [J]. 热带生物学报, 2019, 10(2): 127-134. |
| Li H, Chang WJ, Chen HQ, et al. Functional analysis of the mon1 gene in Fusarium oxysporum f.sp. cubense Race 4 [J]. J Trop Biol, 2019, 10(2): 127-134. | |
| [40] | 王田, 陈代朋, 高雅, 等. 香蕉枯萎病菌效应蛋白研究进展 [J]. 农业生物技术学报, 2022, 30(8): 1614-1621. |
| Wang T, Chen DP, Gao Y, et al. Research progress on the effector of Fusarium oxysporum f.sp. cubense [J]. J Agric Biotechnol, 2022, 30(8): 1614-1621. |
| [1] | SHI Yan-hua, LI Shuo, GAO Yu-zhu, ZHENG Bao-kun, ZHU Jie-hua, ZHANG Dai, YANG Zhi-hui. Analysis of the Growth-promoting Effects and Active Components of Volatile Organic Compounds Produced by Bacillus velezensis NZ-4 [J]. Biotechnology Bulletin, 2025, 41(8): 300-310. |
| [2] | SUN Meng-xue, ZHANG Yi-ying, Xu Peng, SUN Zhuo, WANG Yun-he, HAN Zhong-ming. Isolation and Identification of Endophytic Bacteria from Saposhnikovia divaricata and Analysis of Its Growth-promoting Characteristics [J]. Biotechnology Bulletin, 2025, 41(7): 299-311. |
| [3] | CHEN Yong-qi, LI Zhi-wen, LI Xin, YUAN Ruo-xi, WANG Chun-xu, HAN Yi-qiang, GAO Ya-mei. Isolation and Function Study of Actinomycetes from Rhizosphere Soil of Soybean in the Black Soil Region [J]. Biotechnology Bulletin, 2025, 41(5): 255-266. |
| [4] | FAN Zong-qiang, FENG Jing-han, ZHENG Li-xue, WANG Shuo, PENG Xiang-qian, CHEN Fang. Study on the Control and Induced Resistance in Cucumber with Bacillus subtilis B579 against Cucumber Fusarium Wilt [J]. Biotechnology Bulletin, 2024, 40(7): 226-234. |
| [5] | ZHOU Jiang-hong, XIA Fei, ZHONG Li, QIU Lan-fen, LI Guang, LIU Qian, ZHANG Guo-feng, SHAO Jin-li, LI Na, CHE Shao-chen. Whole Genome Sequencing and Comparative Genomic Analysis of Antagonistic Bacterium CCBC3-3-1 against Verticillium dahlia [J]. Biotechnology Bulletin, 2024, 40(7): 235-246. |
| [6] | WANG Jia-wei, LI Chen, LIU Jian-li, ZHOU Shi-jie, YI Jia-min, YANG Jin-yuan, KANG Peng. Effects of Endophytic Fungal Inoculation on the Seedling Growth of Silage Maize [J]. Biotechnology Bulletin, 2024, 40(4): 189-202. |
| [7] | XU Wei-fang, LI He-yu, ZHANG Hui, HE Zi-ang, GAO Wen-heng, XIE Zi-yang, WANG Chuan-wen, YIN Deng-ke. Efficacy and Its Mechanism of Bacterial Strain HX0037 on the Control of Anthracnose Disease of Trichosanthes kirilowii Maxim [J]. Biotechnology Bulletin, 2024, 40(4): 228-241. |
| [8] | WANG Lu, LIU Meng-yu, ZHANG Fu-yuan, JI Shou-kun, WANG Yun, ZHANG Ying-jie, DUAN Chun-hui, LIU Yue-qin, YAN Hui. Isolation and Identification of Rumen Skatole-degrading Bacteria and Analysis on Their Degradation Characteristics [J]. Biotechnology Bulletin, 2024, 40(3): 305-311. |
| [9] | LI Xi, BIAN Zi-jun, NING Zhou-shen, LIU Hong-yu, ZENG Bing, DONG Wei. Studies on the Growth-promoting Effect of Bacillus Strain from Rhizosphere in Ionic Rare Earth Ores [J]. Biotechnology Bulletin, 2024, 40(11): 259-268. |
| [10] | ZHAO Zhi-xiang, WANG Dian-dong, ZHOU Ya-lin, WANG Pei, YAN Wan-rong, YAN Bei, LUO Lu-yun, ZHANG Zhuo. Control of Pepper Fusarium Wilt by Bacillus subtilis Ya-1 and Its Effect on Rhizosphere Fungal Microbial Community [J]. Biotechnology Bulletin, 2023, 39(9): 213-224. |
| [11] | ZHAO Guang-xu, YANG He-tong, SHAO Xiao-bo, CUI Zhi-hao, LIU Hong-guang, ZHANG Jie. Phosphate-solubilizing Properties and Optimization of Cultivation Conditions of Penicillium rubens: A Highly Efficient Phosphate Solubilizer [J]. Biotechnology Bulletin, 2023, 39(9): 71-83. |
| [12] | JIANG Run-hai, JIANG Ran-ran, ZHU Cheng-qiang, HOU Xiu-li. Research Progress in Mechanisms of Microbial-enhanced Phytoremediation for Lead-contaminated Soil [J]. Biotechnology Bulletin, 2023, 39(8): 114-125. |
| [13] | XU Hong-Yun, LV Jun, YU Cun. Growth Promoting of Pinus massoniana Seedlings Regulated by Rhizosphere Phosphate-solubilizing Paraburkholderia spp. [J]. Biotechnology Bulletin, 2023, 39(6): 274-285. |
| [14] | YANG Dong, TANG Ying. Enzymatic Characterization and Degradation Sites of AFB1 Degradation by the Extracellular Enzyme of Bacillus subtilis Strain WTX1 [J]. Biotechnology Bulletin, 2023, 39(4): 93-102. |
| [15] | YANG Dong-ya, QI Rui-xue LI, Zhao-xuan , LIN Wei, MA Hui, ZHANG Xue-yan. Screening, Identification and Growth-promoting Effect of Antagonistic Bacillus spp. Against Cucumber Fusarium solani [J]. Biotechnology Bulletin, 2023, 39(2): 211-220. |
| Viewed | ||||||
|
Full text |
|
|||||
|
Abstract |
|
|||||